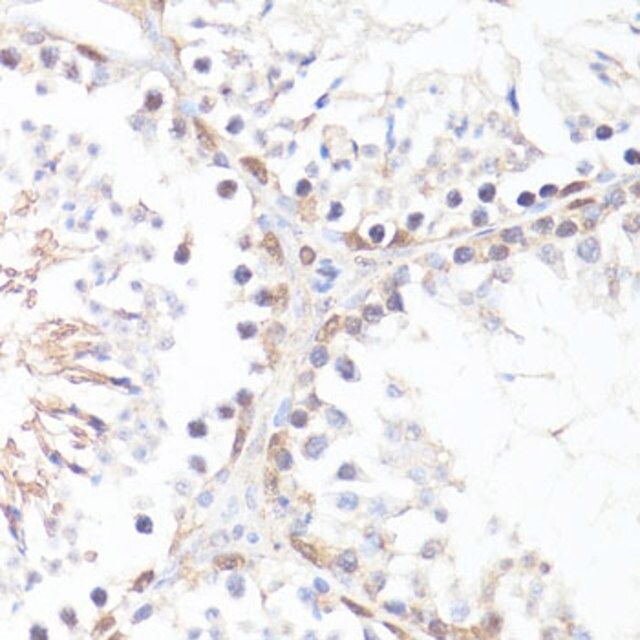

产品说明
一般描述
The protein encoded by this gene is a multifunctional, nuclear phosphoprotein that plays a role in cell cycle progression, apoptosis and cellular transformation. It functions as a transcription factor that regulates transcription of specific target genes. Mutations, overexpression, rearrangement and translocation of this gene have been associated with a variety of hematopoietic tumors, leukemias and lymphomas, including Burkitt lymphoma. There is evidence to show that alternative translation initiations from an upstream, in-frame non-AUG (CUG) and a downstream AUG start site result in the production of two isoforms with distinct N-termini. The synthesis of non-AUG initiated protein is suppressed in Burkitt′s lymphomas, suggesting its importance in the normal function of this gene.
免疫原
A phospho specific peptide corresponding to residues surrounding T58 of human MYC
外形
Buffer: PBS with 0.02% sodium azide,50% glycerol,pH7.3.
产品性质
| 生物来源 | rabbit |
| 质量水平 | 100 |
| antibody product type | primary antibodies |
| 克隆 | polyclonal |
| 形式 | liquid |
| species reactivity | human |
| 浓度 | 4.34 mg/mL |
| technique(s) | immunohistochemistry: 1:50-1:200 western blot: 1:500-1:2000 |
| UniProt登记号 | P01106 |
| 运输 | wet ice |
| 储存温度 | −20℃ |
| Gene Information | human ... MYC(4609) |
安全信息
| 闪点(F) | Not applicable |
| 闪点(C) | Not applicable |